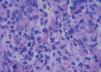

Pentavalent antimonials are the first-line drug treatment for American tegumentary leishmaniasis. We report on a patient with chronic renal failure on hemodialysis who presented with cutaneous lesions of leishmaniasis for four months. The patient was treated with intravenous meglumine under strict nephrological surveillance, but cardiotoxicity, acute pancreatitis, pancytopenia, and cardiogenic shock developed rapidly. Deficient renal clearance of meglumine antimoniate can result in severe toxicity, as observed in this case. These side effects are related to cumulative plasma levels of the drug. Therefore, second-line drugs like amphotericin B are a better choice for patients on dialysis.
American tegumentary leishmaniasis (ATL) is an endemic parasitic disease that in Brazil is caused mostly by Leishmania (Viannia) braziliensis.1 Pentavalent antimonials are the first-line drug treatment for ATL.2,3 Musculoskeletal pain, headache, nausea, and asthenia are reported as common side effects, and cardiotoxicity, hepatotoxicity, nephrotoxicity, and pancreatitis as rare, and associated with cumulative doses. 4-7 The authors report severe side effects associated with the use of meglumine antimoniate (Glucantime®) in a patient presenting chronic renal failure (CRF) due to systemic hypertension, on hemodialysis for two years.
A 42-year-old male patient from São Paulo State, Brazil, complained of rapidly growing cutaneous lesions on the face for four months. Upon examination we observed an ulcerated and verrucous lesion measuring 10.0 cm on the left malar-zygomatic region associated with similar lesions on the lower lip and right infra-au-ricular area. (Figures 1 and 2). Clinical examination was unremarkable. With the hypothesis of paracoccidioidomycosis or leishmaniasis, the patient underwent a biopsy, and the anatomopathological exam showed chronic inflammatory infiltrate with lymphocytes, plasma cells, and epithelioid granulomas. Amastigotes were seen in the cytoplasm of macrophages, confirming leishmaniasis (Figures 3 and 4). Montenegro skin test was positive, measuring 15 x 15mm. Pre-treatment laboratory workup revealed anemia and confirmed the patient's renal failure. Other exams were normal or negative including HIV serology. Following the nephrological evaluation, we initiated Glucantime® 13.5mg/Sbv/kg/IV/daily with the patient hospitalized and under monitored management and routine hemodialysis sessions. On treatment day 5, the patient presented transient supraventricular arrhythmia during Glucantime® administration, which was interrupted. On the same day, the patient developed signs and symptoms of severe acute pancreatitis (Ranson 3), rising liver enzymes, pancytopenia (hemoglobin = 6.9 g/dl; white blood cells = 2600/mm3; platelets = 52000/ mm3), and shock. Transferred to the ICU, the patient quickly recovered from shock under volume replacement and vasoactive drugs, but symptomatic improvement of pancreatitis was slow. Although the antimonial treatment was discontinued, surprisingly the cutaneous lesions nearly vanished in a short period of time. With clinical improvement and a residual lesion, we started amphotericin B deoxycholate 0.5mg/kg/daily on hospital day (HD) 28, in maintenance hemodialysis and support treatment. The patient was discharged on HD 50 in good health and complete resolution of lesions. One year later he was submitted to renal transplantation and is currently in good clinical condition.
Glucantime® is excreted 80% through the kidneys as active drug.8 Therefore, there are strict limits for its use in patients presenting reduced renal clearence.9 Management of this clinical case was initially based on the assumption that hemodialysis would be capable of filtering the antimonial, which did not occur or only occurred partially, resulting in drug accumulation up to 4050 mg/Sbv (810mg/Sbv/day). Consequently, side effects appeared quickly and were severe, particularly cardiotoxicity and pancreatitis. When a patient presents with definitive and total renal failure, the suggestion is to prescribe amphotericin B deoxycholate, which is eliminated mainly by metabolism and is a dialyzable drug, with the liposomal formulation as an alternative.10 A beneficial effect of the high plasma antimonial level was the fast and almost complete resolution of the leishmaniasis cutaneous lesions.